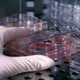
В российское общество клонов не допустят

Анатолий Болтунов
Анатолий Болтунов — корреспондент новостной службы NewsInfo, ведущий информационных программ на радио, редактор, диктор. Главный редактор с мая 2007 по ноябрь 2009 гг.
Болтунов окончил фвкультет культурологии Самарской академии культуры и искусства по специальности "режиссер" (1996-2001гг.)
Март 2003 — Март 2007 заместитель главного редактора Компания телерадиовещания и печати ОАО ''АвтоВАЗ'' (Тольятти) Должность: заместитель главного редактора информационного радио ''Новый Век''.
Апрель 2007 — Ноябрь 2009 ООО ''Медиа Холд'' (РАДИО ХОЛДИНГ) (Москва) — СМИ ведущий информационных программ, редактор Дирекция информационных программ Должность: ведущий информационных программ ''М радио'' ''Х-ФМ''
Март 2010 — Август 2010 Экология Севера (сетевое издание) — СМИ обозреватель, редактор новостной ленты Наполнение сайта актуальными событиями в мире, стране (преимущество экологическим проблемам). Написание и редактирование выпусков новостей. Написание аналитических статей, обзоров, репортажей, интервью на различные темы. Опыт работы с большим объемом информации.
Ноябрь 2009 — Март 2010 Большой бизнес (ежедневное сетевое издание) — обозреватель, редактор новостной ленты "Большой бизнес" — ежедневное сетевое издание, рассказывающее о событиях в экономической жизни России, а также о мировых тенденциях, имеющих отношение к нашей стране. Наполнение контента актуальными событиями в мире, стране. Написание и редактирование выпусков новостей.
Октябрь 2010 — Ноябрь 2011 Русский день общественно-политическое издание (интернет газета) (Москва) — СМИ главный редактор
Ноябрь 2011 — Апрель 2012 интернет-медиахолдинг ЗАО (Москва) — СМИ Редактор новостей видеостудии, корреспондент, диктор/

Материалы автора (2721)
 2010-01-14 15:24.00
2010-01-14 15:24.00
Басманный суд Москвы отказался возобновить следствие по делу экс-главы ОВД "Царицыно" Дениса Евсюкова, обвиняемого в стрельбе по людям в столичном супермаркете в апреле 2009 года. Адвокаты потерпевших намерены оспорить решение в вышестоящей инстанции - Мосгорсуде. Ранее адвокат Игорь Трунов заявлял, что "следствие было проведено неполно, а целому ряду преступных действий обвиняемого не дана соответствующая юридическая оценка".
Читать полностью » 2010-01-14 14:19.00
2010-01-14 14:19.00
Первый русский мэр Риги Нил Ушаков считает бредовой идею правительства Латвии подсчитать ущерб, якобы нанесенный республике в период так называемой "советской оккупации". Кроме того, мэр латвийской столицы Нил Ушаков говорит о скором переименовании в Риге улицы Джохара Дудаева. По мнению Ушакова, улице Дудаева надо дать нейтральное название.
Читать полностью » 2010-01-14 13:35.00
2010-01-14 13:35.00
Армения и Турция дали обязательство ратифицировать в парламентах армяно-турецкие протоколы в разумные сроки. Говоря о том, что подразумевается под "разумными сроками" Налбандян отметил: "Что такое разумные сроки - это то, что не затягивать и не создавать искусственных препятствий". Кроме этого, мнению главы МИД РФ Лаврова, застоя в процессе нагорно-карабахского урегулирования нет.
Читать полностью » 2010-01-14 12:43.00
2010-01-14 12:43.00
Суд Киева признал виновными в голоде 1932-1933 годов руководителей большевиков. Иосиф Сталин является одним из главных обвиняемых. Украинские коммунисты неоднократно заявляли о фальсификации "дела о голодоморе". В частности, на многочисленных выставках, организованных СБУ, были представлены фотографии времен Первой мировой войны и начала 1920-годов, а данные о числе умерших в некоторых областях превышали численность населения.
Читать полностью » 2010-01-14 12:02.00
2010-01-14 12:02.00
Владимир Путин утвердил антиалкогольную концепцию, в рамках которой государство рассчитывает за 10 лет более чем вдвое снизить потребление алкогольной продукции в стране и добиться полного исчезновения нелегального алкогольного рынка. Снижения потребления алкоголя на душу населения на 55% к 2020 году планируется достичь за счет реализации пакета мер.
Читать полностью » 2010-01-13 17:11.00
2010-01-13 17:11.00
Госдума намерена поддержать законопроект о продлении до 2012 года запрета на клонирование человека. Документ поддержан РАН и РАМН. Мораторий на клонирование закончился 23 июня 2007 года, а сам закон был принят в 2002 году. В соответствии с декларацией ООН о клонировании человека было принято решение продлить мораторий на пять лет.
Читать полностью » 2010-01-13 15:05.00
2010-01-13 15:05.00
На МКС возникли проблемы с эксплуатацией системы очистки воды. Система перерабатывает мочу астронавтов в обычную питьевую воду. Проблемы с эксплуатацией системы очистки воды на МКС могли возникнуть из-за высокого содержания кальция в моче астронавтов, приводящего к засорению устройства стоимостью 250 миллионов долларов.
Читать полностью » 2010-01-13 13:42.00
2010-01-13 13:42.00
Сторонники кандидатов в президенты Украины, выборы которого состоятся 17 января, не смогут проводить митинги на площади Независимости в центре Киева в день голосования, а также до и после него из-за запрета Окружного административного суда столицы. Решение о запрете было принято по просьбе Киевской горадминистрации. Причины такой просьбы не называются.
Читать полностью » 2010-01-13 12:06.00
2010-01-13 12:06.00
Замглавы МИД Израиля Данни Аялон пообещал в будущем использовать "более приемлемые дипломатические средства". Аудиенцию у Аялона, который выражал протест против показа по турецкому телевидению "антиизраильского" сериала, турецкий посол назвал самым унизительным эпизодом за три десятка лет своей дипломатической карьеры.
Читать полностью » 2010-01-13 10:52.00
2010-01-13 10:52.00
Американская поисковая система Google может прекратить работу в Китае в связи с хакерской атакой. Google заявляет, что у нее есть свидетельства того, что «основной целью хакеров был доступ к Gmail-аккаунтам активистов по борьбе за права человека в Китае». Компания обнаружила попытку вскрыть эти аккаунты в декабре прошлого года.
Читать полностью » 2010-01-13 10:04.00
2010-01-13 10:04.00
Накануне недалеко от берегов Гаити - самой бедной страны западного полушария, с небольшим интервалом произошли два сильных землетрясения магнитудой 7,0 и 5,9 соответственно. В Порт-о-Пренс разрушено здание президентского дворца, почти полностью разрушено здание штаб-квартиры миротворческой миссии ООН. Сотни людей, по оценкам местных медиков, могут считаться погибшими.
Читать полностью » 2010-01-12 15:48.00
2010-01-12 15:48.00
Глава МИД Испании председательствующей в ЕС пообещал, что россияне смогут ездить в Европу без виз. Руководитель российского МИД Сергей Лавров призвал ЕС четко обозначить сроки перехода к безвизовому режиму и заявил, что рассчитывает значительный на прогресс по этому вопросу в самое ближайшее время. Против отмены европейских виз для россиян выступают страны Прибалтики.
Читать полностью »




